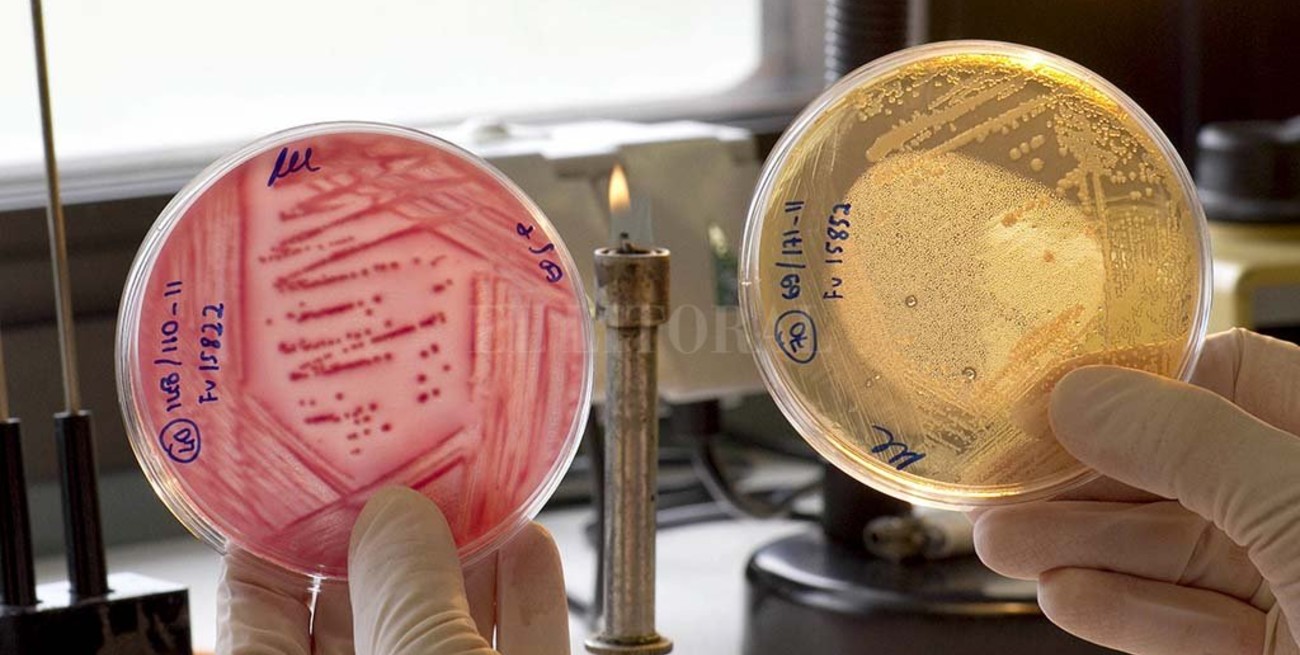

El Litoral | [email protected]
Preocupan los altos niveles de resistencia a antibióticos
Un equipo de la OMS vigila, a nivel global, la evolución de un problema que agrava el riesgo de las infecciones bacterianas. Hay bacterias que toleraran penicilina y ciprofloxacino, entre otros fármacos.

Los primeros datos publicados por la Organización Mundial de la Salud (OMS) sobre la vigilancia de la resistencia a los antibióticos indican que los niveles de resistencia a algunas infecciones bacterianas graves son elevados tanto en los países de ingresos altos como en los de ingresos bajos.
El nuevo Sistema Mundial de Vigilancia de la Resistencia a los Antimicrobianos de la OMS, denominado Glass por sus siglas en inglés, ha revelado la presencia generalizada de resistencia a los antibióticos en muestras de 500 000 personas de 22 países en las que se sospechaban infecciones bacterianas.
Las bacterias resistentes más frecuentes son Escherichia coli, Klebsiella pneumoniae, Staphylococcus aureus y Streptococcus pneumoniae, seguidas de Salmonella spp. El sistema no incluye datos sobre las resistencias de Mycobacterium tuberculosis (el bacilo que causa la tuberculosis), del que la OMS hace un seguimiento desde 1994 y del que publica actualizaciones anuales en su Informe Mundial sobre la Tuberculosis.
En los pacientes en los que se sospechó una infección sanguínea se observó una amplia variación entre países en la proporción de los que presentaban resistencias bacterianas al menos a uno de los antibióticos más utilizados, desde un 0% hasta un 82%.
La resistencia a la penicilina, el fármaco utilizado durante décadas en todo el mundo para tratar la neumonía, osciló entre un 0% y un 51% en los países estudiados. Además entre un 8% y un 65% de las muestras de E. coli, una bacteria que causa infecciones de las vías urinarias, presentaban resistencia al ciprofloxacino, un antibiótico utilizado habitualmente para tratar estas infecciones.
El Dr. Marc Sprenger, director de la secretaría para la resistencia a los antimicrobianos de la OMS, señaló que el informe confirma la grave situación que representa la resistencia a los antibióticos en todo el mundo. “Estamos comprobando que algunas de las infecciones más frecuentes y peligrosas son farmacorresistentes. Lo que resulta más preocupante es que estos patógenos no respetan las fronteras nacionales”, planteó.
El Sistema Mundial de Vigilancia de la Resistencia a los Antimicrobianos de la OMS incluye actualmente a 52 países (25 de ingresos altos, 20 de ingresos medianos y siete de ingresos bajos). Para este primer informe, 40 países proporcionaron información sobre sus sistemas nacionales de vigilancia y 22 países facilitaron también datos sobre sus niveles de resistencia a los antibióticos.
La Dra. Carmem Pessoa-Silva, coordinadora de este nuevo sistema en la OMS, explicó que el informe es un primer paso fundamental para mejorar nuestro conocimiento del alcance de la resistencia a los antibióticos. “Esta vigilancia está todavía en ciernes, pero es indispensable desarrollarla si queremos anticiparnos y atajar una de las mayores amenazas para la salud pública mundial”, advirtió.
Los datos presentados en este primer informe Glass varían mucho tanto en calidad como en integralidad. Algunos países encuentran problemas importantes para establecer su sistema nacional de vigilancia, entre ellos la falta de personal, presupuestos e infraestructuras.
Durante muchos años, los sólidos programas de vigilancia de la resistencia a los antimicrobianos para la tuberculosis, la infección por el VIH y el paludismo han ayudado a estimar la morbimortalidad por estas enfermedades, planificar los servicios de diagnóstico y tratamiento, conocer la eficacia de las intervenciones efectuadas y determinar pautas eficaces de tratamiento para frenar las resistencias y evitar que aparezcan en el futuro. Lo OMS espera que el sistema Glass funcione de modo similar para la vigilancia de las bacterias patógenas más habituales.
Antecedentes
La necesidad de establecer un sistema mundial de vigilancia se puso de manifiesto en el informe mundial de la OMS sobre la vigilancia de la resistencia a los antimicrobianos de 2014.
En octubre de 2015, la OMS puso en marcha el Sistema Mundial de Vigilancia de la Resistencia a los Antimicrobianos (Glass). Para ello, trabajó estrechamente con sus centros colaboradores y con las redes existentes de vigilancia de esta resistencia, y se basó en su propia experiencia con otros programas de vigilancia, por ejemplo el sistema de vigilancia de la farmacorresistencia a los medicamentos antituberculosos, que se viene aplicando en 188 países durante los últimos 24 años, y el sistema de vigilancia de las resistencias a los fármacos utilizados para tratar la infección por el VIH, que se puso en marcha en 2005.
En 2017, este sistema había recibido datos sobre pretratamiento y resistencias adquiridas de más de 50 países, utilizando métodos de encuesta normalizados.